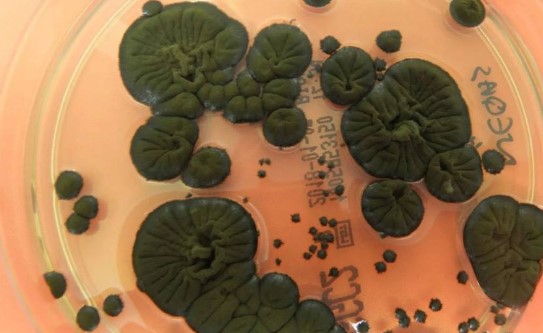
На ЧАЕС грибок «живиться» радіацією

У ЧАЕС знайшли грибок, який «живиться» радіацією.
Cladosporium sphaerospermum не просто виживає під високими дозами випромінювання – він використовує його як джерело енергії завдяки меланіну. На МКС цей гриб ріс на 20% швидше, ніж на Землі.
Науковці вже розглядають його як потенційну основу для нових радіаційних щитів і навіть самовідновних «мікобудівель» у майбутніх космічних колоніях.